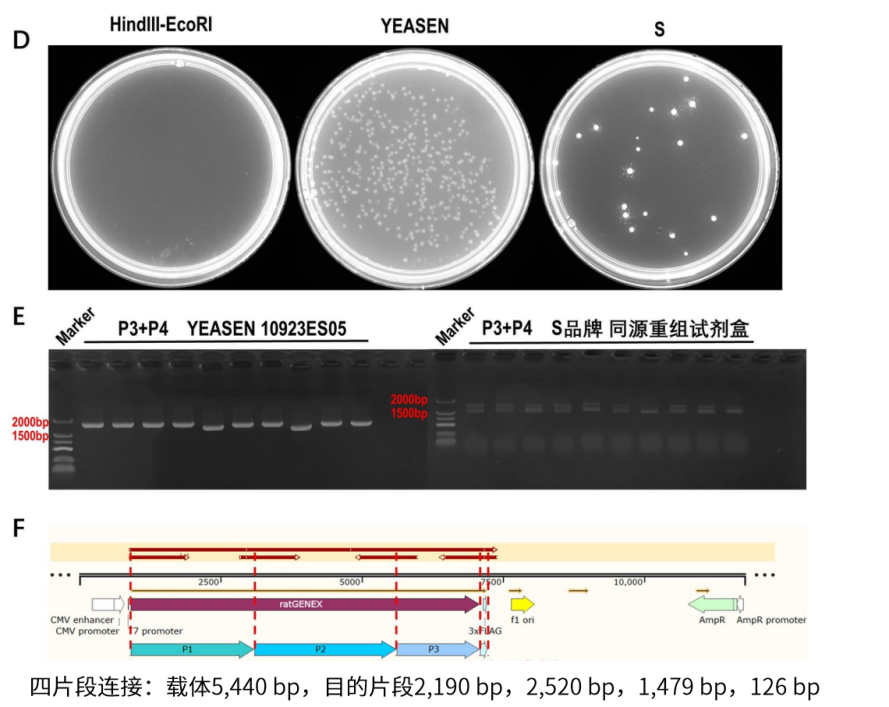
Nature重磅突破!武汉大学严欢团队解锁病毒研究新钥匙,首推人工定制化受体!

18 年
手机商铺
入驻年限:18 年
翌圣生物
上海
体外诊断、耗材、技术服务、抗体、ELISA 试剂盒、细胞库 / 细胞培养、试剂
生产厂商
公司新闻/正文
357 人阅读发布时间:2025-03-23 14:32
在2024年的今天,冠状病毒这个名字已经成为了全球性的焦点。从SARS到MERS,再到如今的COVID-19,冠状病毒家族以其强大的变异能力和广泛的宿主范围,不断挑战着人类的健康防线。然而,由于缺乏有效的感染模型,许多冠状病毒的研究和疫苗开发工作进展缓慢。今天,小翌要介绍的是一项革命性的研究成果——定制化冠状病毒受体(CVRs),它为冠状病毒的研究打开了新的大门。
冠状病毒的挑战
冠状病毒以其多样的受体和复杂的感染机制,给科学家们带来了巨大的挑战。传统的研究方法依赖于已知的受体和感染模型,但对于那些尚未明确受体的冠状病毒,这种方法显得力不从心。此外,冠状病毒的快速变异能力使得研究和防控工作更加困难。
定制化冠状病毒受体的诞生
在这一背景下,2024年10月30日,武汉大学生命科学学院严欢团队的刘鹏等人在《Nature》(IF:50.5)杂志上发表了一项突破性研究——“Design of customized coronavirus receptors”。这项研究提出了一种全新的策略,通过工程化手段设计出能够模拟天然受体功能的定制化冠状病毒受体(CVRs)。该研究证明了CVR策略在建立天然受体非依赖性感染模型方面的潜力,为研究缺乏已知易感靶细胞的病毒提供了一种工具。

定制化受体的设计原理
CVRs的设计基于“乐高积木”的模块化设计思路,通过构建人工受体框架(ARSs)和特定的病毒结合域(VBDs),实现了对冠状病毒的特异性识别和结合。这种设计不仅能够模拟天然受体的功能,还能够根据需要进行调整和优化,以适应不同的研究和应用场景。

图1.CVRs的模块化设计策略示意图及其技术潜在应用(图片来自原文)
关键因素的发现
研究团队通过一系列实验,确定了CVRs功能性模仿天然受体的关键因素。首先,研究者们创建了四个hACE2嵌合蛋白,用微蛋白LCB1或LCB3逐步替换ACE2的头部到颈部域,通过真实的SARS-CoV-2感染实验,证明这些嵌合蛋白有效地支持病毒感染,且促进伪病毒进入的能力会随着ACE2的缩短而逐渐减弱(如图2 d所示)。通过实验确定了影响CVRs功能性的关键因素,包括VBD与病毒刺突蛋白的结合亲和力、CVRs在细胞表面的表达水平、以及CVRs诱导病毒刺突蛋白构象变化的能力。

图2.解析ACE2序列对其病毒受体功能的重要性(图片来自原文)
接着,研究员利用22种已知的SARS-CoV-2中和抗体,这些抗体覆盖了一系列中和表位,将它们转换成基于scFv(单链可变片段)的病毒结合域(VBDs),从而构建了44个CVRs。除了76E1纳米抗体(它识别的表位在受体结合后才会暴露)之外,所有CVRs在系统中都表现出良好的表达,并且能够有效地结合到SARS-CoV-2的刺突蛋白三聚体上(如图3所示)。

图3.结合表位对受体功能的影响(图片来自原文)
之后,研究者们通过S2L20-CVR(定制化冠状病毒受体)来促进SARS-CoV-2(严重急性呼吸综合征冠状病毒2)的进入,并且证明这种进入是通过刺突蛋白的N末端域(NTD)介导的。强调了CVRs设计中功能性表位的重要性,揭示了由N末端域靶向的S2L20-CVR促进的细胞进入机制,并揭示了这些表位与病毒进入和膜融合过程之间的关系。通过这些发现,研究人员能够更好地理解CVRs如何促进病毒感染,并为进一步优化CVRs设计提供了重要的信息。
实验验证
研究者们成功地为来自6个不同亚属的12种冠状病毒设计了具有功能性的CVRs,其中大多数冠状病毒缺乏已知受体。研究人员通过生物层干涉法(BLI)测定,确定了所选纳米抗体与12种冠状病毒抗原的结合动力学(如图4所示)。

图4.纳米抗体与固定化病毒抗原结合的结合动力学(图片来自原文)
为了评估CVR对多轮病毒繁殖的支持,研究者们用HKU3或HKU5刺突蛋白替换VSV-G基因,创建了具有传播能力的重组水疱性口炎病毒(pcVSVs)。如图5所示,实验结果表明,即使在没有VSV-G的情况下,CVRs表达的细胞依旧可以支持病毒的进入和传播(c-d),支持病毒的持续复制和释放(e-f)。这些CVRs能够有效支持病毒的传播和复制,证明了CVRs策略在建立不依赖于天然受体的感染模型中的潜力。

图5.CVRs在支持多种冠状病毒复制和扩增方面的能力(图片来自原文)
最后,研究人员使用CVRs表达细胞成功分离和培养了难以培养的真实冠状病毒,例如RsHuB2019A,这是一种不依赖ACE2的蝙蝠沙贝科病毒。实验结果表明,CVRs表达的细胞可以支持真实冠状病毒的扩增。这些数据为CVRs在冠状病毒研究和潜在的抗病毒策略中的应用提供了有力的证据。
CVRs的应用前景
病毒学研究的新工具
疫苗开发的新途径
通过CVRs,研究人员可以在没有天然受体的情况下,评估疫苗候选物对病毒的中和能力。这不仅加快了疫苗筛选的速度,还提高了疫苗开发的成功率。
CVRs还可以用于筛选和评估抗病毒药物,特别是对于那些难以在传统细胞模型中研究的冠状病毒。通过CVRs,研究人员可以更准确地评估药物的抗病毒效果,为临床治疗提供科学依据。
定制化冠状病毒受体(CVRs)的研究成果,为我们打开了一扇通往冠状病毒研究新世界的大门。它不仅提供了研究这些神秘病毒的新工具,便于更深入地理解冠状病毒的感染机制,还能加速疫苗和抗病毒药物的开发,同时为全球公共卫生安全提供了新的保障,并为未来可能出现的冠状病毒疫情提供了研究基础。随着科学研究的不断深入,我们有理由相信,CVRs将在未来的冠状病毒防控中发挥越来越重要的作用。
翌圣助力产品
在该研究中,研究人员选择了翌圣Hieff Clone®系列克隆试剂盒用于构建表达载体,包括所有表达I型跨膜CVRs的质粒构建。

(截图来自原文)
克隆产品推荐
|
方法 |
产品定位 |
产品名称 |
产品货号 |
规格 |
|
载体构建 |
1-7片段一步法定向连接,最快5分钟完成重组反应 |
Hieff Clone® Universal II One Step Cloning Kit |
10923ES20/50 |
20 T/50 T |

图6. Hieff Clone® Universal II One Step Cloning Kit四片段连接,高GC和短片段组合连接,相比于S品牌,10923菌落数多,阳性率100%。D:重组转化平板。E:插入片段测序鉴定图。F:Sanger测序证明1载体与4片段连接成功,连接处测序正确。
相关产品推荐
|
方法 |
产品定位 |
产品名称 |
产品货号 |
规格 |
|
|
目的片段扩增 |
5s/kb,保真保快 |
2× Hieff Canace® AdvanceFast PCR Master Mix (With Dye) |
10164ES03/08 |
1 mL/5×1 mL |
|
|
感受态转化 |
5 min快速完成感受态转化 |
F DH5α化学感受态 |
11803ES80 |
10×100 μL |
|
|
阳性克隆鉴定 |
快速PCR升级,可菌P且适用复杂模板扩增 |
2×Hieff® Ultra-Rapid II HotStart PCR Master Mix |
10167ES03/08 |
1 mL/5×1 mL |
|
|
目的片段保存 |
兼容TA/平末端克隆 |
Hieff Clone® Universal Zero TOPO TA/Blunt Cloning Kit |
10906ES20
|
20 T |